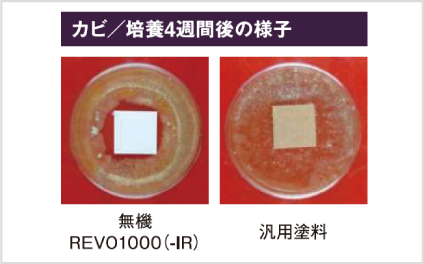

外壁
無機REVO1000-IR
建物を永く美しく守るために作られた
次世代型ハイクラス遮熱無機塗料
次世代型ハイクラス遮熱無機塗料
建物を永く美しく守るためには耐候性、低汚染性、遮熱性に優れた塗料で塗替えすることが不可欠。
無機REVO1000-IRはそれらの性能を高いレベルで実現するため塗料中に使用する無機成分や顔料を徹底的にこだわり抜きました。
無機REVO1000-IRはそれらの性能を高いレベルで実現するため塗料中に使用する無機成分や顔料を徹底的にこだわり抜きました。
-
期待耐用年数20~22年
-
低汚染性〇
-
遮熱性〇
-
防水性-
-
防カビ・防藻性〇
-
色69色

製品スペック
機能
色・事例
製品仕様
特長
耐候性
紫外線などの劣化要因に対して耐候性を発揮し、建物を長期間保護
促進耐候性試験(キセノンランプ式)において約20~22年(期待耐用年数)経過後も光沢保持率80%以上を保持。塗膜の劣化要因である紫外線・雨に対して、高い耐候性を発揮し、建物を長期間保護します。
※あくまで試験環境下における推測値であり、耐候性を保証するものではありません。実際の自然ばく露環境下では、下地の状態、施工方法、気象条件により耐候性は異なる場合があります。
※あくまで試験環境下における推測値であり、耐候性を保証するものではありません。実際の自然ばく露環境下では、下地の状態、施工方法、気象条件により耐候性は異なる場合があります。

HALS含有 有機無機ハイブリッド樹脂により高い耐候性を実現
無機塗料は紫外線による影響を受けづらく、劣化に非常に強い性質を持つ無機成分が含まれています。しかし、無機成分だけでは、強い塗料は生まれません。なぜなら無機成分の割合が高いと塗膜が硬くなりやすく、ひび割れの原因になることがあるからです。その弱点を解決するために、なくてはならないのが有機成分のしなやかさです。無機REVO1000-IRで使用されている樹脂は、強力な結合エネルギーをもつ無機成分のコア層をHALS(光安定剤)が配合された特殊な有機成分のシェル層で覆うことで、高い耐候性、強靭性、柔軟性を兼ね備えました。

ラジカル制御型の白色顔料を配合
一般的に塗料で使用される白色顔料の主成分「酸化チタン」は、紫外線の影響を受けると「ラジカル」と呼ばれる劣化要因を発生させます。その劣化要因が発生すると、樹脂の結合が破壊され、塗膜が劣化してしまいます。無機REVO1000-IRはこのラジカルの発生を抑制する「ラジカル制御型白色顔料」を採用。ラジカルが発生しにくく、発生した場合にも、シールド層がラジカルの放出を防ぐため、樹脂が破壊されにくく、劣化を抑制します。

<ラジカル制御型白色顔料>
ラジカルが発生しにくく、発生した場合もシールド層がラジカルの放出を抑える。
ラジカルが発生しにくく、発生した場合もシールド層がラジカルの放出を抑える。

<一般的な白色顔料>
発生したラジカルにより、塗膜が破壊。
発生したラジカルにより、塗膜が破壊。
特長
低汚染性
汚れの付着を抑制し、建物の美観を維持
無機REVO1000-IRは無機成分配合により、劣化に強く、汚れにくい緻密で強靭な塗膜を形成しています。微細な汚染物質さえも突き刺さりにくいため、建物の美観を維持します。

<無機REVO100シリーズ>
塗膜表面が強靭なため、砂埃が刺さりにくく、排気ガスなどが染み込みにくい。
塗膜表面が強靭なため、砂埃が刺さりにくく、排気ガスなどが染み込みにくい。

<一般的な塗料>
塗膜表面の強靭性に乏しく砂埃が突き刺さり、排気ガスが染み込む。
塗膜表面の強靭性に乏しく砂埃が突き刺さり、排気ガスが染み込む。

カビ・藻の発生を抑え、 建物の美観維持に貢献
「JIS Z 2911かび抵抗性試験方法(社内試験規格)」及び「藻抵抗性試験(社内試験による)」に合格。カビ・藻の発生を抑え、美観の維持に貢献します。

特長
遮熱性
高い日射反射率で室内の温度上昇を抑え、生活環境を快適に
太陽光の波長のうち温度上昇の主な原因となるのは近赤外線(波長:780~2500nm)。
無機REVO1000-IRは一般的な塗料の着色に使用されているカーボンブラック等よりも日射反射率が高く、熱を吸収しにくい「特殊遮熱無機顔料」を使用。※1 近赤外線を効果的に反射する塗膜を形成し、室内の温度上昇を抑制。※2生活環境の快適化に貢献します。
※1 アステック標準色の色番号8113(トゥルーホワイト)を除く全色で使用。
※2 建物構造、断熱構造、開口部(ガラス窓)の大きさ・数によって温度変化の程度に差が出ます。
無機REVO1000-IRは一般的な塗料の着色に使用されているカーボンブラック等よりも日射反射率が高く、熱を吸収しにくい「特殊遮熱無機顔料」を使用。※1 近赤外線を効果的に反射する塗膜を形成し、室内の温度上昇を抑制。※2生活環境の快適化に貢献します。
※1 アステック標準色の色番号8113(トゥルーホワイト)を除く全色で使用。
※2 建物構造、断熱構造、開口部(ガラス窓)の大きさ・数によって温度変化の程度に差が出ます。
遮熱効果の高い「特殊遮熱無機顔料」を採用

近赤外線を反射し塗膜の表面温度の上昇を抑制。

近赤外線を反射できず塗膜の表面温度が上昇。

よくある質問
ハウスメーカーで建てた家ですが、アステックペイント塗料で塗装工事はできますか?







































































